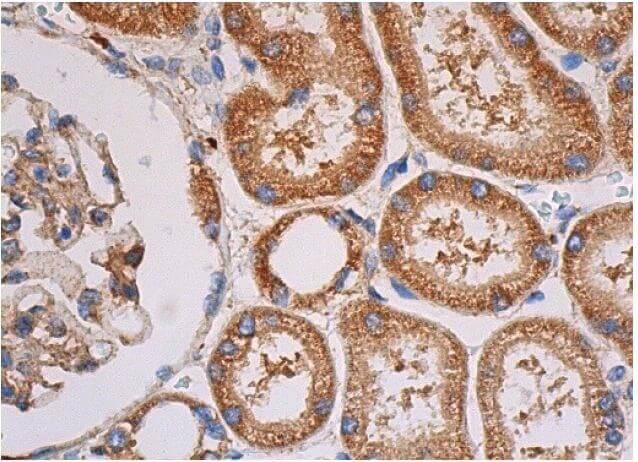

マイストア
変更
お店で受け取る
(送料無料)
配送する
納期目安:
06月04日頃のお届け予定です。
決済方法が、クレジット、代金引換の場合に限ります。その他の決済方法の場合はこちらをご確認ください。
※土・日・祝日の注文の場合や在庫状況によって、商品のお届けにお時間をいただく場合がございます。
特価 p-p38-antibody-e-1-western- アイドルグッズの詳細情報
p-p38-antibody-e-1-western-。p-p38 MAPK Antibody (E-1) | SCBT - Santa Cruz Biotechnology。PICOZX motherboard for ZX Spectrum original case from。PICOZX - Handheld ZX Spectrum 128k + other 8bits from。
商品説明
他の方からのご購入は御遠慮ください
商品情報
出品者情報
ベストセラーランキングです
近くの売り場の商品
カスタマーレビュー
オススメ度 4.6点
現在、3876件のレビューが投稿されています。

/i/7289/products/2024-10-23T06:04:13.024Z-IMG_1555.JPG?1729638322)






/i/7289/products/2024-10-23T06:19:36.431Z-IMG_1538.JPG?1729639282)
/i/7289/products/2023-04-28T21:38:39.075Z-1679522577127.jpg)














